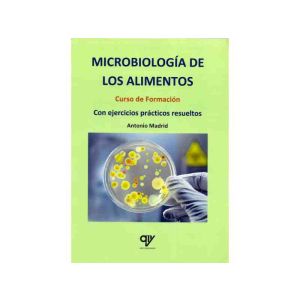
Foto_variante

Nutrición y suplementos
Tenemos una cuidadosa selección de suplementos alimenticios y suplementos nutricionales diseñados para ayudarte a mantener una alimentación equilibrada y mejorar tu bienestar general.
En Quirumed, creemos en la importancia de una alimentación natural, por eso ofrecemos una variedad de suplementos alimenticios naturales que te brindarán los nutrientes esenciales que necesitas de manera saludable. Nuestra colección de productos incluye opciones de calidad, respaldadas por la investigación científica, para ayudarte a complementar tu dieta y alcanzar tus metas de bienestar.
Además de los suplementos naturales, en nuestra categoría de Nutrición y Suplementos también encontrarás una amplia gama de productos relacionados con la nutrición y dietética. Nuestra selección de productos dietéticos te ofrece opciones nutritivas y sabrosas para distintas necesidades, como control de peso, intolerancias alimentarias o dietas específicas.
En la sección Alimentación natural puedes descubrir nuestros productos orgánicos y naturales, elaborados con ingredientes de alta calidad y libres de aditivos artificiales.
En la sección de Complementos alimenticios te invitamos a que encuentres una amplia gama de suplementos nutricionales diseñados para complementar tu dieta y brindar el soporte necesario para mantener un estilo de vida saludable.
En Quirumed, nos esforzamos por ofrecer productos de calidad que se ajusten a tus necesidades individuales. Ya sea que estés buscando mejorar tu salud, mantener un peso equilibrado o apoyar tus objetivos de bienestar, nuestra sección de Nutrición y Suplementos tiene todo lo que necesitas.
¡Descubre nuestra selección de suplementos alimenticios naturales y productos dietéticos hoy mismo, y da un paso más hacia una vida saludable!
-
 Educación para el Conteo de Hidratos de CarbonoAs low as 42,00 € IVA excl. 34,71 €En stock - Envío 24/48 hVendido por Axon Librería
Educación para el Conteo de Hidratos de CarbonoAs low as 42,00 € IVA excl. 34,71 €En stock - Envío 24/48 hVendido por Axon Librería -
 Educacion Sanitaria en Alimentacion y NutricionAs low as 23,21 € IVA excl. 19,18 €En stock - Envío 24/48 hVendido por Axon Librería
Educacion Sanitaria en Alimentacion y NutricionAs low as 23,21 € IVA excl. 19,18 €En stock - Envío 24/48 hVendido por Axon Librería -
 Bioquímica de la Carne. Curso de Formación. Con Ejercicios Prácticos Resueltos, Esquemas de Flujo, Tablas y GráficosAs low as 30,95 € IVA excl. 25,58 €En stock - Envío 24/48 hVendido por Axon Librería
Bioquímica de la Carne. Curso de Formación. Con Ejercicios Prácticos Resueltos, Esquemas de Flujo, Tablas y GráficosAs low as 30,95 € IVA excl. 25,58 €En stock - Envío 24/48 hVendido por Axon Librería -
 WILLIAMS Nutrición Básica y DietoterapiaAs low as 65,10 € IVA excl. 53,80 €En stock - Envío 24/48 hVendido por Axon Librería
WILLIAMS Nutrición Básica y DietoterapiaAs low as 65,10 € IVA excl. 53,80 €En stock - Envío 24/48 hVendido por Axon Librería -
 Fisiología de la NutriciónAs low as 50,07 € IVA excl. 41,38 €En stock - Envío 24/48 hVendido por Axon Librería
Fisiología de la NutriciónAs low as 50,07 € IVA excl. 41,38 €En stock - Envío 24/48 hVendido por Axon Librería -
 Manual de Lineamientos para Practica de Nutricion Clinica. Enfermedades Cronico-DegenerativasAs low as 47,81 € IVA excl. 39,51 €En stock - Envío 24/48 hVendido por Axon Librería
Manual de Lineamientos para Practica de Nutricion Clinica. Enfermedades Cronico-DegenerativasAs low as 47,81 € IVA excl. 39,51 €En stock - Envío 24/48 hVendido por Axon Librería -
 Análisis Sensorial de Alimentos y Respuesta del ConsumidorAs low as 49,74 € IVA excl. 41,11 €En stock - Envío 24/48 hVendido por Axon Librería
Análisis Sensorial de Alimentos y Respuesta del ConsumidorAs low as 49,74 € IVA excl. 41,11 €En stock - Envío 24/48 hVendido por Axon Librería -
 Manual de Biotecnologia de los EnzimasAs low as 49,73 € IVA excl. 41,10 €En stock - Envío 24/48 hVendido por Axon Librería
Manual de Biotecnologia de los EnzimasAs low as 49,73 € IVA excl. 41,10 €En stock - Envío 24/48 hVendido por Axon Librería -
 Diabetes MellitusAs low as 42,01 € IVA excl. 34,72 €En stock - Envío 24/48 hVendido por Axon Librería
Diabetes MellitusAs low as 42,01 € IVA excl. 34,72 €En stock - Envío 24/48 hVendido por Axon Librería -
 Guía de Diagnóstico y Tratamiento de la FenilcetonuriaAs low as 31,91 € IVA excl. 26,37 €En stock - Envío 24/48 hVendido por Axon Librería
Guía de Diagnóstico y Tratamiento de la FenilcetonuriaAs low as 31,91 € IVA excl. 26,37 €En stock - Envío 24/48 hVendido por Axon Librería -
 Errores en Nutricion InfantilAs low as 35,47 € IVA excl. 29,31 €En stock - Envío 24/48 hVendido por Axon Librería
Errores en Nutricion InfantilAs low as 35,47 € IVA excl. 29,31 €En stock - Envío 24/48 hVendido por Axon Librería -
 Pierde Peso sin Perder la CabezaAs low as 30,95 € IVA excl. 25,58 €En stock - Envío 24/48 hVendido por Axon Librería
Pierde Peso sin Perder la CabezaAs low as 30,95 € IVA excl. 25,58 €En stock - Envío 24/48 hVendido por Axon Librería -
 La Química en tu CocinaAs low as 27,64 € IVA excl. 22,84 €En stock - Envío 24/48 hVendido por Axon Librería
La Química en tu CocinaAs low as 27,64 € IVA excl. 22,84 €En stock - Envío 24/48 hVendido por Axon Librería -
Microbiología de los Alimentos. Curso de Formación. Con Ejercicios Prácticos ResueltosAs low as 35,37 € IVA excl. 29,23 €En stock - Envío 24/48 hVendido por Axon Librería
Microbiología de los Alimentos. Curso de Formación. Con Ejercicios Prácticos ResueltosAs low as 35,37 € IVA excl. 29,23 €En stock - Envío 24/48 hVendido por Axon Librería -
 Dieta Cetógena en el Tratamiento de la EpilepsiaAs low as 39,66 € IVA excl. 32,78 €En stock - Envío 24/48 hVendido por Axon Librería
Dieta Cetógena en el Tratamiento de la EpilepsiaAs low as 39,66 € IVA excl. 32,78 €En stock - Envío 24/48 hVendido por Axon Librería -
 Manual de Practicas de BromatologiaAs low as 25,74 € IVA excl. 21,27 €En stock - Envío 24/48 hVendido por Axon Librería
Manual de Practicas de BromatologiaAs low as 25,74 € IVA excl. 21,27 €En stock - Envío 24/48 hVendido por Axon Librería -
 Manual de Nutrición en el Niño con Enfermedad NeurológicaAs low as 50,42 € IVA excl. 41,67 €En stock - Envío 24/48 hVendido por Axon Librería
Manual de Nutrición en el Niño con Enfermedad NeurológicaAs low as 50,42 € IVA excl. 41,67 €En stock - Envío 24/48 hVendido por Axon Librería -
 Endocrinología InfantilAs low as 35,37 € IVA excl. 29,23 €En stock - Envío 24/48 hVendido por Axon Librería
Endocrinología InfantilAs low as 35,37 € IVA excl. 29,23 €En stock - Envío 24/48 hVendido por Axon Librería -
 Tratado de Nutrición, Tomo 4: Nutrición Humana en el Estado de la SaludAs low as 126,00 € IVA excl. 104,13 €En stock - Envío 24/48 hVendido por Axon Librería
Tratado de Nutrición, Tomo 4: Nutrición Humana en el Estado de la SaludAs low as 126,00 € IVA excl. 104,13 €En stock - Envío 24/48 hVendido por Axon Librería -
 Cursos Crash. Lo Esencial en Metabolismo y NutriciónAs low as 51,56 € IVA excl. 42,61 €En stock - Envío 24/48 hVendido por Axon Librería
Cursos Crash. Lo Esencial en Metabolismo y NutriciónAs low as 51,56 € IVA excl. 42,61 €En stock - Envío 24/48 hVendido por Axon Librería -
 Manual Oxford de Endocrinología y DiabetesAs low as 66,22 € IVA excl. 54,73 €En stock - Envío 24/48 hVendido por Axon Librería
Manual Oxford de Endocrinología y DiabetesAs low as 66,22 € IVA excl. 54,73 €En stock - Envío 24/48 hVendido por Axon Librería -
 La Cocina de la Salud. el Manual para Disfrutar de una Vida SanaAs low as 24,20 € IVA excl. 20,00 €En stock - Envío 24/48 hVendido por Axon Librería
La Cocina de la Salud. el Manual para Disfrutar de una Vida SanaAs low as 24,20 € IVA excl. 20,00 €En stock - Envío 24/48 hVendido por Axon Librería -
 Manual Práctico de Dietoterapia del NiñoAs low as 37,58 € IVA excl. 31,06 €En stock - Envío 24/48 hVendido por Axon Librería
Manual Práctico de Dietoterapia del NiñoAs low as 37,58 € IVA excl. 31,06 €En stock - Envío 24/48 hVendido por Axon Librería -
 Trastornos de la Conducta Alimentaria y ObesidadAs low as 39,08 € IVA excl. 32,30 €En stock - Envío 24/48 hVendido por Axon Librería
Trastornos de la Conducta Alimentaria y ObesidadAs low as 39,08 € IVA excl. 32,30 €En stock - Envío 24/48 hVendido por Axon Librería
Tenemos una cuidadosa selección de suplementos alimenticios y suplementos nutricionales diseñados para ayudarte a mantener una alimentación equilibrada y mejorar tu bienestar general.
En Quirumed, creemos en la importancia de una alimentación natural, por eso ofrecemos una variedad de suplementos alimenticios naturales que te brindarán los nutrientes esenciales que necesitas de manera saludable. Nuestra colección de productos incluye opciones de calidad, respaldadas por la investigación científica, para ayudarte a complementar tu dieta y alcanzar tus metas de bienestar.
Además de los suplementos naturales, en nuestra categoría de Nutrición y Suplementos también encontrarás una amplia gama de productos relacionados con la nutrición y dietética. Nuestra selección de productos dietéticos te ofrece opciones nutritivas y sabrosas para distintas necesidades, como control de peso, intolerancias alimentarias o dietas específicas.
En la sección Alimentación natural puedes descubrir nuestros productos orgánicos y naturales, elaborados con ingredientes de alta calidad y libres de aditivos artificiales.
En la sección de Complementos alimenticios te invitamos a que encuentres una amplia gama de suplementos nutricionales diseñados para complementar tu dieta y brindar el soporte necesario para mantener un estilo de vida saludable.
En Quirumed, nos esforzamos por ofrecer productos de calidad que se ajusten a tus necesidades individuales. Ya sea que estés buscando mejorar tu salud, mantener un peso equilibrado o apoyar tus objetivos de bienestar, nuestra sección de Nutrición y Suplementos tiene todo lo que necesitas.
¡Descubre nuestra selección de suplementos alimenticios naturales y productos dietéticos hoy mismo, y da un paso más hacia una vida saludable!




